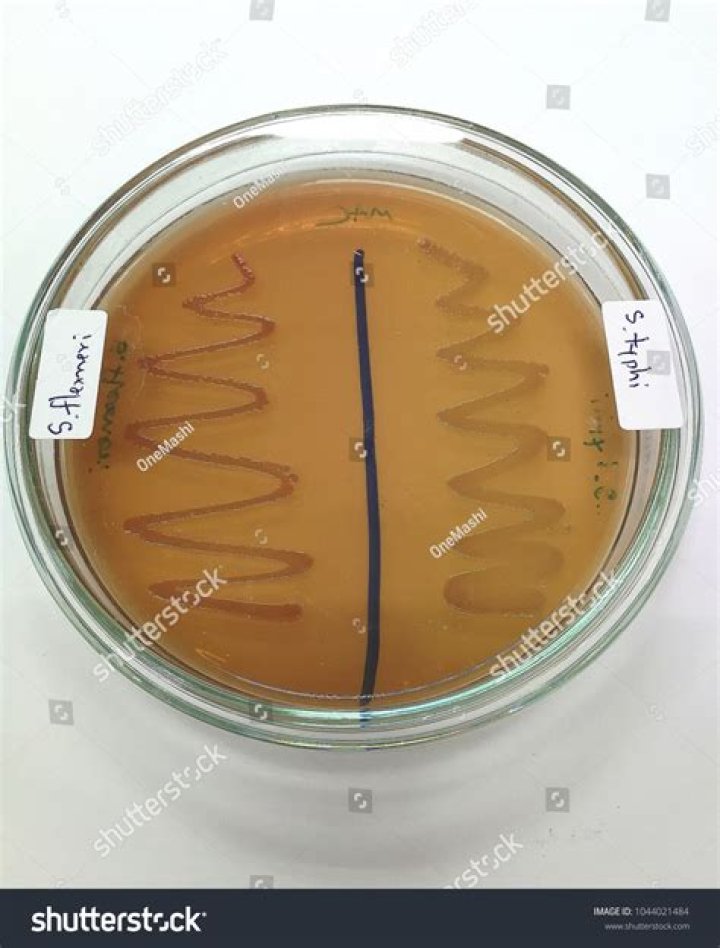

Can salmonella grow on MacConkey Agar

Ava Hall
Published Mar 03, 2026
OrganismsGrowth resultsSalmonella, ShigellaColorless colonies, or sometime medium color: orange to amberPseudomonasIrregular, colorless to pink colonies
What bacteria grows on MacConkey agar?
Altogether, MacConkey agar only grows gram-negative bacteria, and those bacteria will appear differently based on their lactose fermenting ability as well as the rate of fermentation and the presence of a capsule or not.
What grows best on MacConkey agar?
MacConkey’s is a selective medium that inhibits the growth of Gram-positive bacteria due to the presence of crystal violet and bile salts. Gram-negative bacteria grow well on MAC.
Why is MacConkey agar used for salmonella?
MacConkey agar is used for the isolation of gram-negative enteric bacteria and the differentiation of lactose fermenting from lactose non-fermenting gram-negative bacteria.What gram-negative rods do not grow on MacConkey agar?
Long, thin, slowly growing, oxidase-positive, catalase-positive gram-negative rods that do not grow on MacConkey agar should suggest DF-2. Although testing of antimicrobial susceptibility is problematic, DF-2 has been found to be resistant to aminoglycosides.
Can Bacillus species grow on MacConkey Agar?
The strain of Bacillus subtilis found on MacConkey agar and Chapman agar medium did not grow; however, it grow better on TSA agar medium containing 5% fetal calf serum with circular ridges, smooth, moist, sticky and medium-sized colonies.
Does Salmonella ferment lactose?
It has been reported that less than 1% of all salmonellae ferment lactose (17). Since 1907, there have been various reports of the occurrence of lactose-fermenting (Lac+) Salmonella in humans, such as Lac+ Salmonella enterica serotype Virchow, S.
Will Klebsiella grow on MacConkey agar?
Klebsiella pneumoniae is a Gram-negative, non-motile, encapsulated, lactose-fermenting, facultative anaerobic, rod-shaped bacterium. It appears as a mucoid lactose fermenter on MacConkey agar. … It naturally occurs in the soil, and about 30% of strains can fix nitrogen in anaerobic conditions.Does Salmonella typhimurium grow on MacConkey agar?
⇒ Special requirements – Salmonella typhi or S. typhi have no complex nutritional requirements and readily grow in an ordinary media like Nutrient Agar medium (NAM). Commonly the NAM & MacConkey Agar medium is used for the cultivation of Salmonella typhi in Laboratory.
Why is MacConkey agar yellow?Organisms unable to ferment lactose will form normal-colored (i.e., un-dyed) colonies. The medium will remain yellow. Examples of non-lactose fermenting bacteria are Salmonella, Proteus species, Yersinia, Pseudomonas aeruginosa and Shigella.
Article first time published onCan E coli grow on MacConkey agar?
MacConkey agar not only selects for Gram-negative organisms by inhibiting Gram-positive organisms and yeast but also differentiates the Gram-negative organisms by lactose fermentation. … Escherichia coli and other lactose ferments will produce yellow or orange colonies.
What are some potentially pathogenic bacteria that grow on MacConkey agar and do not ferment lactose?
Colonies that do not change the pH of media: Salmonella, Proteus species, Yersinia, Pseudomonas aeruginosa, and Shigella are examples of this group. These bacteria do not ferment lactose; hence neutral red does not change to pink.
Does Staphylococcus aureus grow on MacConkey agar?
MacConkey agar selects for organisms like Escherichia coli (Gram negative bacilli) while inhibiting the growth of organisms like Staphylococcus aureus (Gram positive cocci).
Is Salmonella Gram-negative?
Salmonella species are Gram-negative, flagellated facultatively anaerobic bacilli characterized by O, H, and Vi antigens. There are over 1800 known serovars which current classification considers to be separate species.
Why there is no growth on MacConkey Agar?
MacConkey Agar (MAC) is a selective and differential medium designed to isolate and differentiate enterics based on their ability to ferment lactose. Bile salts and crystal violet inhibit the growth of Gram positive organisms. … Micrococcus luteus does not grow in the presence of bile salts and crystal violet.
Does Pseudomonas grow on MacConkey Agar?
Apart from the media mentioned above, Pseudomonas aeruginosa can also be grown in MacConkey agar (a bacterial culture medium commonly used to grow lactose fermenting bacteria). … In MacConkey agar, Pseudomonas aeruginosa forms flat and smooth colonies that are between 2 and 3mm in diameter.
What color is Salmonella on MacConkey Agar?
OrganismsGrowth resultsEnterobacter, KlebsiellaMucoid, pink coloniesProteusColorless colonies, swarming growthSalmonella, ShigellaColorless colonies, or sometime medium color: orange to amberPseudomonasIrregular, colorless to pink colonies
What media does Salmonella grow on?
The most commonly used media selective for Salmonella are SS agar, bismuth sulfite agar, Hektoen enteric (HE) medium, brilliant green agar and xylose-lisine-deoxycholate (XLD) agar.
Is Salmonella a typhi?
Salmonella Typhi (S. Typhi) are bacteria that infect the intestinal tract and the blood. The disease is referred to as typhoid fever.
Will Bacillus subtilis grow on MacConkey agar?
MacConkey Agar Plate Record observations here on the growth and appearance of the three bacteria on MacConkey agar. Bacillus subtilis No or very little growth. Escherichia coli Heavy growth; pink to red. Pseudomonas fluorescens Heavy growth; not pink or red.
Does Serratia marcescens grow on MacConkey agar?
Gram stain: Serratia species are Gram-negative rods. Culture: S. marcescens grows well on blood agar and MacConkey agar. It is non-lactose fermenting.
What are the sugars present in MacConkey agar?
The selective ingredients are the bile salts and the dye, crystal violet which inhibit the growth of Gram-positive bacteria. The differential ingredient is lactose. Fermentation of this sugar results in an acidic pH and causes the pH indicator, neutral red, to turn a bright pinky-red color.
Is Salmonella typhi aerobic or anaerobic?
Salmonella is a facultative anaerobe that can grow in a broad range of environmental conditions. The organism is also an intracellular pathogen that must survive an oxidative burst during infection, and negotiate anaerobic and aerobic environments.
Can Enterobacter aerogenes grow on MacConkey Agar?
On MacConkey agar, E. cloacae and E. aerogenes commonly appear as pink, lactose-fermenting, mucoid colonies similar in appearance to Klebsiella pneumoniae and K.
How does Klebsiella look on MacConkey agar?
Laboratory Identification of Klebsiella pneumoniae colonies are pink (LF), mucoid (usually), and 3 to 4 mm in diameter. Colonies on Hektoen enteric agar and XLD are yellow. Large, mucoid, glistening pink colonies on a MacConkey agar plate, typical of the colonies produced by many Klebsiella and Enterobacter spp.
What does Pseudomonas aeruginosa look like on MacConkey agar?
P. aeruginosa produces colonies with a characteristic “grape-like” or “fresh-tortilla” odor on bacteriological media. In mixed cultures, it can be isolated as clear colonies on MacConkey agar (as it does not ferment lactose) which will test positive for oxidase.
Does Alcaligenes faecalis grow on MacConkey agar?
Can grow on MacConkey agar and Simmons’ citrate agar. Isolated from soil, water, feces, urine, blood, sputum,wounds, pleural fluid, nematodes, and insects. Subsp.
What will a bacterium that does not ferment lactose look like on MacConkey Agar?
(Entero-bacteria aerogenes) No fermentation (no lactose) results in PINK colonies on medium and produce COLORLESS colonies which because of their transparency appear to take on the PURPLE color of the medium. What is MacConkey Agar used for?
Does Neisseria grow on MacConkey?
Note: Neisseria does not grow on MacConkey. Note: Growth, but no fermentation of lactose. Colorless colonies, medium is slightly yellow due to the increased pH resulting from bacterial digestion of peptone in the medium. Note: Gram-positives do not grow on MacConkey.
Does Escherichia coli ferment lactose?
Background. E. coli are facultative anaerobic, Gram-negative bacilli that will ferment lactose to produce hydrogen sulfide. Up to 10% of isolates have historically been reported to be slow or non-lactose fermenting, though clinical differences are unknown.
What would you expect to see if you cultured Gram positive lactose fermenting bacteria on MacConkey Agar?
what do you expect to see on MacConkey agar medium? lactose fermenting bacteria produce colonies that are various shades of red because of the conversion of the nuetral red indicator dye (red below pH 6.8) from the production of mixed acids.



